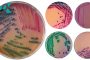
تخصصی ترین مقایسه ( پکیج زمینی با کوره هوای گرم )برای بهترین انتخاب سالن های صنعتی

پکیج زمینی یا کوره هوای گرم کدام یک از سیستم های گرمایشی صنعتی برای شما مناسب ترین می باشد؟ پاسخ به این سوال مستلزم مقایسه تخصصی و فنی کوره هوای گرم با پکیج زمینی است که قصد داریم با این مقایسه شما را در انتخاب بهترین سیستم گرمایشی همراهی کنیم؛ تامین یک سیستم گرمایشی، فقط بخاطر آسایش کارمندان یک مجموعه باشد و فرد اهمیتی برای بررسی و انتخاب بهترین آنها ندهد. اما همین توجه به آسایش کارکنان، تاثیر بسزایی در راندمان و نتیجه نهایی کار دارد. از طرفی، وجود سیستم گرمایش، یکی از پارامترهای اصلی در عملکرد برخی از فضاهای وسیع مثل گلخانه یا مرغداریهاست. پس میتوان گفت بدون وجود آنها، کارکرد صنایع با اختلال روبرو خواهد شد. البته هر سیستم گرمایشی نمیتواند عملکرد لازم و قابل قبول در تمام فضاها را داشته باشد. پس باید با تمام دستگاههای گرمایش قابل استفاده در مکان های مختلف و ویژگیهای آنها آشنا شوید تا بتوانید بهترین و کاربردیترین را انتخاب کنید.
روی سخن مطلب پیش رو در مورد 2 سیستم حرارتی پکیج زمینی و کوره هوای گرم است که توسط کارشناسان فنی تیم تولید صنایع ماشین سازی هیمورا تدوین شده است. اما قابلیتها و ویژگیهای هرکدام متفاوت از دیگری است و هریک برتریها و مزایایی دارند که شاید قابل قیاس با دیگری نباشد. در این مقاله، هر 2 سیستم گرمایشی از تمام ابعاد بررسی شدهاند تا بتوانید سازگارترین آنها را که با شرایط محیط شما مطابقت دارد، انتخاب کنید. همچنین هر یک از آنها قابلیتهایی دارند که شاید دیگری فاقد آن باشد و نتواند در تامین نیازهای گرمایشی کمک کند و یا آن قابلیت اصلا کاربردی نبوده و لازم نباشد هزینه اضافی بابت آن خرج شود.
مقدمه
کوره هوای گرم و پکیج زمینی ، 2 سیستم گرمایش رایج در اماکن با ابعاد بزرگ و صنعتی هستند. با وجود اینکه تفاوتهای بارز و بسیاری میان آنها وجود دارد، اما شباهتهایی هم دارند که آنها را به 2 سیستم رقیب در صنعت حرارتی تبدیل کرده است. نمیتوان ویژگی خوب یا بد بودن را به طور مطلق برای یک دستگاه اختصاص داد. علت این امر این است که هر دستگاه مطابق با ویژگیهای یک محیط خاص طراحی شده است؛ اما شاید هیچ کاربردی در محیطی با شرایط و ویژگیهای دیگر نداشته باشد. بنابراین تمام ویژگیهای این 2 دستگاه صنعتی را در کنار هم آورده و مقایسه کردهایم تا بتوانید سیستم گرمایشی مطابق با نیاز خود را گزینش نمایید.
چگونه بهترین سیستم برای گرمایش سالنهای صنعتی انتخاب کنیم؟
نحوه گرمایش، تهویه و سرمایش سالنهای بزرگ صنعتی، به یکی از معضلات صاحبان و کارمندان آن مجموعه بدل گشته است. برای روبه رو نشدن با این مشکلات، باید در ابتدای امر و قبل از راهاندازی سالن، به فکر تعبیه این نوع سیستمها بود. فراهم کردن این تجهیزات در داخل سوله و سالنها به قدری اهمیت دارد که در صورت عدم وجود آنها، نمیتوانید از پس انجام کارها بر بیایید. برای تامین سیستم گرمایش مناسب سالنهای صنعتی به سبب حجم بزرگ و ساعت کاری زیاد، باید دقت بیشتری انجام داد. برای صرفه جویی در هزینهها و ایجاد گرمایش مناسب، همه روزه سیستمهای متنوعتری طراحی و روانه بازار میشود که مصرف کننده باید بتواند از میان آنها دستگاهی را انتخاب کند که بیشترین سازگاری را با مکان موردنظر داشته باشد.
از آنجایی که پکیج زمینی و کوره هوای گرم، 2 سیستم رایج و پرطرفدار در گرمایش سالنهای صنعتی هستند، این مقاله را به مقایسه آنها اختصاص دادهایم. با وجود اینکه هر 2 سیستم، قابلیت تامین گرمایش محیطی در فضاهای صنعتی را دارند، اما ویژگیهای کاملا متمایزی دارند که مصرف کننده باید با آنها آشنا باشد و بهترین آنها را انتخاب کند.

هیتر کابینتی یا کوره هوای گرم؟
یکی از رایجترین تجهیزات گرمایشی مورد استفاده در سولههای صنعتی، هیترهای کابینتی هستند که معمولا به اسم “ کوره هوای گرم ” هم شناخته میشوند. این گرمازاها با قابلیت مصرف سوخت گازی و گازوئیلی طراحی و تولید شدهاند که قادرند در کمترین زمان ممکن، کل سولهای را که متراژ آن متناسب با ظرفیت دستگاه است، گرم کرده و به دمای مطلوب برسانند. این هیترها خود هم منبع گرما و هم سیستم پخش حرارت هستند. یعنی هم محفظه احتراق در داخل آنها قرار دارد و هم پخش حرارت به سمت محیط از طریق فن آنها انجام میشود. پس هیتر کوره ای یک سیستم مستقل است که بدون نیاز به لولهکشی، فضا را گرم میکند. همچنین امکان کانالکشی برای هدایت گرما به فضایی دیگر از طریق این سیستمها هم وجود دارد.
گرمای تولید شده از این دستگاهها با خروج دود و گازهای آلاینده همراه است که از طریق دودکش به بیرون از ساختمان هدایت میشود.
پکیج زمینی را بهتر بشناسید!
پکیجهای زمینی از دیگر منابع گرمایشی هستند که در سالنهای صنعتی به کار میروند. این دستگاههای حرارتی صنعتی، منبع تولید گرما هستند که در مدلهای پکیج برقی ، دو گانهسوز (گازی و گازوئیلی) و سه گانهسوز (برقی، گازی و گازوئیلی) طراحی شدهاند. پکیجها به آب لولهکشی متصل هستند و با گرم کردن و انتقال آب به سیستمهای پخش گرما، به عنوان مبداء و مرجع گرما عمل میکنند. در واقع پکیج، به تنهایی نمیتواند در گرم کردن محیط نقشی داشته باشد؛ بلکه حرارت را تامین و به آب وارد میکند و آب گرم در سیستمهای پخش کننده حرارتی مانند رادیاتور شوفاژها و سیستم گرمایش از کف سیرکوله میشود. یکی از مزایای پکیجها، دوکاره بودن آنهاست. به این صورت که هم به گرم کردن فضا کمک کرده و هم آب گرم موردنیاز برای مصرف و استحمام را تامین میکنند.
پس پکیج زمینی یک سیستم مستقل نیست و برای ایفای نقش خود نیاز به همکاری با دستگاههای دیگر دارد. برای اینکه متوجه فرق میان دو سیستم گرمایشی مذکور، یعنی پکیج زمینی و هیتر کابینتی شوید، تصمیم داریم در ادامه متن، به طور مفصلتر به شباهتها و تفاوتهای آنها بپردازیم. این اطلاعات به خریدار کمک میکند که بتواند بهترین و کاربردیترین دستگاه را انتخاب نماید.
پکیج زمینی بخرم یا کوره هوای گرم؟
این دو دستگاه رایج در گرمایش فضاهای صنعتی، کاملا جدا از هم هستند و ویژگیهای متفاوتی دارند. برای اینکه متوجه تفاوت و برتری هریک نسبت به دیگری شوید، بخشی در این مقاله آوردهایم که به طور کامل راهنماییتان میکند.
1.نوع سوخت مصرفی
برای مقایسه دو دستگاه مدنظر، لازم است که نوع سوخت قابل مصرف آنها را بشناسید. زیرا ممکن است مکان شما دسترسی به سوخت تعیین شده برای دستگاه را نداشته باشد.
پکیجهای زمینی
این سیستمهای حرارتی صنعتی، هم از برق و هم سوختهای فسیلی برای تامین گرما استفاده میکنند. مدلهای برقی با کمک المنت و مدلهای گازی و گازوئیلی آنها با کمک مشعل، حرارت را تولید میکنند. علاوه بر پکیج تمام برقی زمینی، مدلهای دو گانهسوز با گاز و گازوئیل و سه گانهسوز که هم مشعل دارند و هم المنت، یعنی هم از برق و هم گاز و گازوئیل استفاده میکنند، دو نمونه دیگر پکیجهای زمینی هستند.

کوره هوای گرم
این مدل از سیستمهای حرارتی، فقط با دو سوخت گازی و گازوئیلی مشتعل میشوند. علت این امر به توان حرارتی بالای آنها، برمیگردد؛ چراکه حتی برق صنعتی هم نمیتواند از عهده این ظرفیت گرمایشی بر بیاید.
2.قابلیتها
هریک از این دو سیستم، ویژگیها و قابلیتهای مخصوص به خود را در گرم کردن محیط دارند. خریدار بهتر است آنها را شناسایی کرده و دستگاهی را تهیه کند که ویژگیهای آن بیشترین کارایی را با محیط داشته باشند.
پکیجهای زمینی
پکیجها از دو قابلیت تامین آب گرم مصرفی و گرمایش محیط به طور همزمان برخوردارند. پس اگر تامین هر دو مورد برایتان اهمیت دارد، بهتر است پکیجها را در اولویت خرید قرار دهید.
کوره هوای گرم
تمرکز عملکرد این هیترها، فقط روی گرم کردن محیط میچرخد. به همین جهت، توان و بازده گرمایش آنها بسیار بالاست. البته هیترهای کابینتی بجای استفاده از لولهکشی، قابلیت کانالکشی دارند. بدین ترتیب شما میتوانید با کشیدن کانال، بهترین استفاده را از گرمای قابل توجه تولیدی ببرید.
3.استقلال
برخی از تجهیزات گرمایشی بدون نیاز به سایر دستگاههای جانبی عمل میکنند.
پکیجهای زمینی
این تجهیزات به تنهایی هیچ کاربردی ندارند. در واقع تمام انواع پکیجها یک منبع برای تامین گرمایش آّب هستند و بدون داشتن سیستم پخش حرارت، هیچ گرمایی از خود پکیج دریافت نخواهد شد. پس در کنار خرید پکیج، باید دستگاههایی مثل شوفاژ یا فن کوئل هم تهیه شود.
کوره هوای گرم
این وسیله گرمایشی بدون نیاز به دستگاه جانبی عمل میکند. در واقع کوره هوای گرم یک دستگاه کاملا جداگانه و بدون لوله کشی و اتصالات است که هم منبع درون آن قرار دارد و هم سیستم پخش حرارت از خودش است.
4.تفاوت در محل نصب
پکیج های زمینی به دلیل اینکه نیاز به گرم کردن آب دارند؛ باید به سیستم لولهکشی محل موردنظر نزدیک باشند. بنابراین مکانی مجزا و دور از محل اصلی مانند یک اتاقک جداگانه میتواند محل نصب این دستگاهها باشد. اما چون گرمای تولیدی هیترهای کابینتی باید سریعا کل فضا را در بگیرد، میتوانند داخل محوطه اصلی و یا خارج از سالن و در یک فضای باز بیرون از محوطه اصلی به کار گرفته شوند.
5.سایز
اندازه و ابعاد هر نوع سیستم و کالایی که برای یک محیط خریداری میشود، باید از نظر خریدار بررسی شود. زیرا امکان دارد با متراژ فضای شما هماهنگی نداشته باشد و مجبور به تعویض آن شوید. برای مقایسه سایز پکیج زمینی و کوره هوای گرم در شرایط ثابت و ظرفیت برابر، باید گفت که تفاوت فاحشی در ابعاد و سایز آنها مشاهده نمیشود. پس بهتر است از نظر ابعاد آنها را مقایسه نکنیم.
6.قدرت گرمایش
یکی از مهمترین پارامترهایی که باید به آن توجه شود، قدرت گرمایش هر سیستم حرارتی است. توان گرمایشی یک دستگاه تحت تاثیر عوامل بسیاری از جمله ابعاد فضا، سیستم تهویه و آب و هوای آن منطقه است. برای یک محیط ثابت در شرایط یکسان، ظرفیت دو سیستم مد نظر، متفاوت در نظر گرفته میشود. اگر قرار باشد یک فضای مشخص را به دمای ایدهآل برسانیم، از ظرفیت گرمایشی کمتری برای پکیجهای زمینی و قدرت حرارتی بیشتر برای کوره هوای گرم استفاده میشود. زیرا پرت حرارتی یا همان هدر رفت گرما در هیترهای کابینتی بیشتر است و برای رساندن محیط به دمای مطلوب توسط آنها، باید ظرفیتهای بیشتر را در نظر بگیریم.
7.قیمت
اگر بخواهیم فقط قیمت دو دستگاه مذکور یعنی پکیج زمینی و هیتر کابینتی را در ظرفیتهای یکسان بررسی کنیم، باید گفت که قیمت پکیج کمتر از کوره هوای گرم است اما از آنجایی که پکیجها مستقل نیستند و نیاز به تجهیزات دیگری هم برای گرمایش دارند، هزینه ای که برای کل مجموعه پکیجها برآورد میشود، بیشتر از یک کوره هوای گرم مستقل است.
سخن پایانی
دو نوع از گرمازاهای صنعتی که بیش از سایر سیستمهای گرمایشی کاربرد و خواهان دارند، کورههای هوای گرم و پکیجهای زمینی هستند. اولین دسته، یعنی کوره هوای گرم، تجهیزاتی با قدرت گرمایش بالا هستند که حرارت را به کمک سوخت فسیلی تامین میکنند و آن را از طریق فن، به بیرون پرتاب میکنند. پس سیستمهایی هستند که گرمای دمنده دارند و انتقال حرارت در آنها به صورت همرفتی و جابه جایی هوای گرم و سرد نیست. این دستگاهها هیچ متعلقاتی نداشته و بدون وابستگی، تمام عملیات را انجام میدهند.
پکیجهای زمینی نیز در کنار تامین گرمایش محیط، آب گرم مصرفی هم تولید میکنند؛ اما یک سیستم مجزا نیستند و به لولهکشی و سیستمهای پخش حرارت و شیرهای تولید آب گرم نیاز دارند. این دستگاهها، هم از سوخت فسیلی و هم برق برای تامین حرارت استفاده میکنند. اگر یک پکیج به فن کوئل متصل باشد، گرمای آن دمنده و اگر به رادیاتور متصل باشد، گرمای همرفتی تولید میکند.